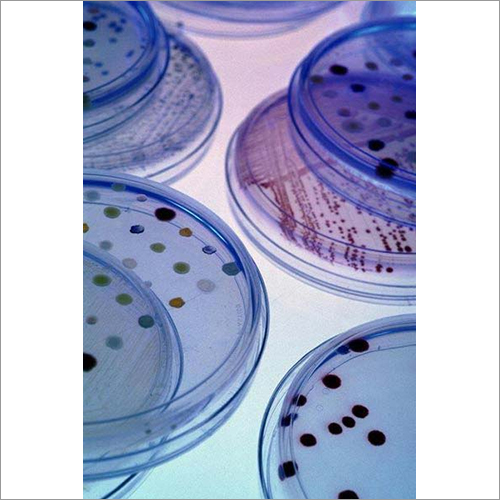
बैक्टीरियोलॉजिकल पेप्टोन

पेप्टोन किण्वन
प्राइस: 100 INR
स्टॉक में
| ग्रेड | Bio-Tech and Technical Grade |
| रंग | White, |
| नमी (%) | 6.0 % |
| प्रोडक्ट का नाम | Peptones |
| शुद्धता (%) | 99 %, |
विस्तृत जानकारी
| ग्रेड | Bio-Tech and Technical Grade |
| रंग | White, |
| नमी (%) | 6.0 % |
| प्रोडक्ट का नाम | Peptones |
| शुद्धता (%) | 99 %, |
| राज्य | सॉलिड |
| शेप | ओवेल, दूसरा |
| रासायनिक नाम | , अन्य |
| स्टोरेज | Room Temperature |
| एप्लीकेशन | Industrial |
| डिलीवरी का समय | 7दिन |
| मुख्य घरेलू बाज़ार | ऑल इंडिया |
| भुगतान की शर्तें | कैश एडवांस (CA), चेक, कैश इन एडवांस (CID) |
| पैकेजिंग का विवरण | Bags. |
| मुख्य निर्यात बाजार | ऑस्ट्रेलिया, पूर्वी यूरोप, मिडल ईस्ट, मध्य अमेरिका, अफ्रीका, पश्चिमी यूरोप, एशिया, उत्तरी अमेरिका, दक्षिण अमेरिका |
| नमूना उपलब्ध | 1 |
| नमूना नीति | मुफ्त नमूने उपलब्ध हैं |
| आपूर्ति की क्षमता | 10प्रति दिन |
कंपनी का विवरण
व्यापार के प्रकार
निर्माता, निर्यातक, आपूर्तिकर्ता
कर्मचारी संख्या
40
स्थापना
1978
कार्य दिवस
सोमवार से रविवार
जीएसटी सं
27AADCS2682N1ZU
विक्रेता विवरण
सुबोनेयो चेमिकल्स फार्मास्युटिकल्स प्राइवेट लिमिटेड
जीएसटी सं
27AADCS2682N1ZU
रेटिंग
4
नाम
स. चौधरी
पता
ा ८६-८९ म.ी.डी.स., इंडस्ट्रियल एरिया, जलगांव, महाराष्ट्र, 425003, भारत
गलत विवरण की रिपोर्ट करें
संबंधित उत्पाद
कैल्शियम कैसिनेट आयु समूह: वयस्क
MOQ - 100 Kilograms/Kilograms
अकोला चेमिकल्स ी लिमिटेड
मुंबई, Maharashtra
पेडीक्योर डाइटरी सप्लीमेंट्स
Price - 880 INR
MOQ - 100000 Piece/Pieces
धीर हैल्थकारे प्राइवेट लिमिटेड
मुंबई, Maharashtra
ए ग्रेड 100 प्रतिशत शुद्धता वाली दवा ग्रेड केमिकल फ्री कोलेकैल्सिफ़ेरॉल ग्रेन्यूल्स पाउडर
Price - 49 INR
MOQ - 20 Piece/Pieces
medmate life science pvt ltd
मुंबई, Maharashtra
विटामिन से भरपूर हर्बल फूड सप्लीमेंट्स आयु समूह: वयस्क
MOQ - 20 Bottle/Bottles
कृषिविश्वा एग्रीटेक पवत. ल्टड.
अहमदनगर, Maharashtra
प्रोटीन पाउडर
Price - 2000 INR
MOQ - 100 Kilograms/Kilograms
bio floyds pharma private limited
पुणे, Maharashtra